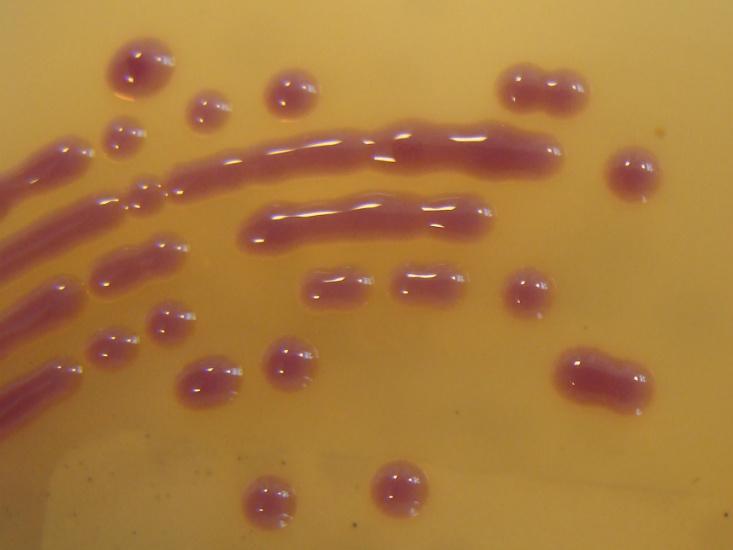

Brandon Keim
BK
Brandon Keim (Substack | Instagram |Bluesky | Mastodon) is a freelance journalist and contributing editor at Nautilus. His new book, Meet the Neighbors, explores what the science of animal intelligence means for how we understand and live with the wild creatures around us.
The Wild, Secret Life of New York City
Get back to nature, right in your own neighborhood.
September 15, 2014
The Lightning Beneath Our Feet
The strange lights that occur before earthquakes may originate underground.
March 5, 2014